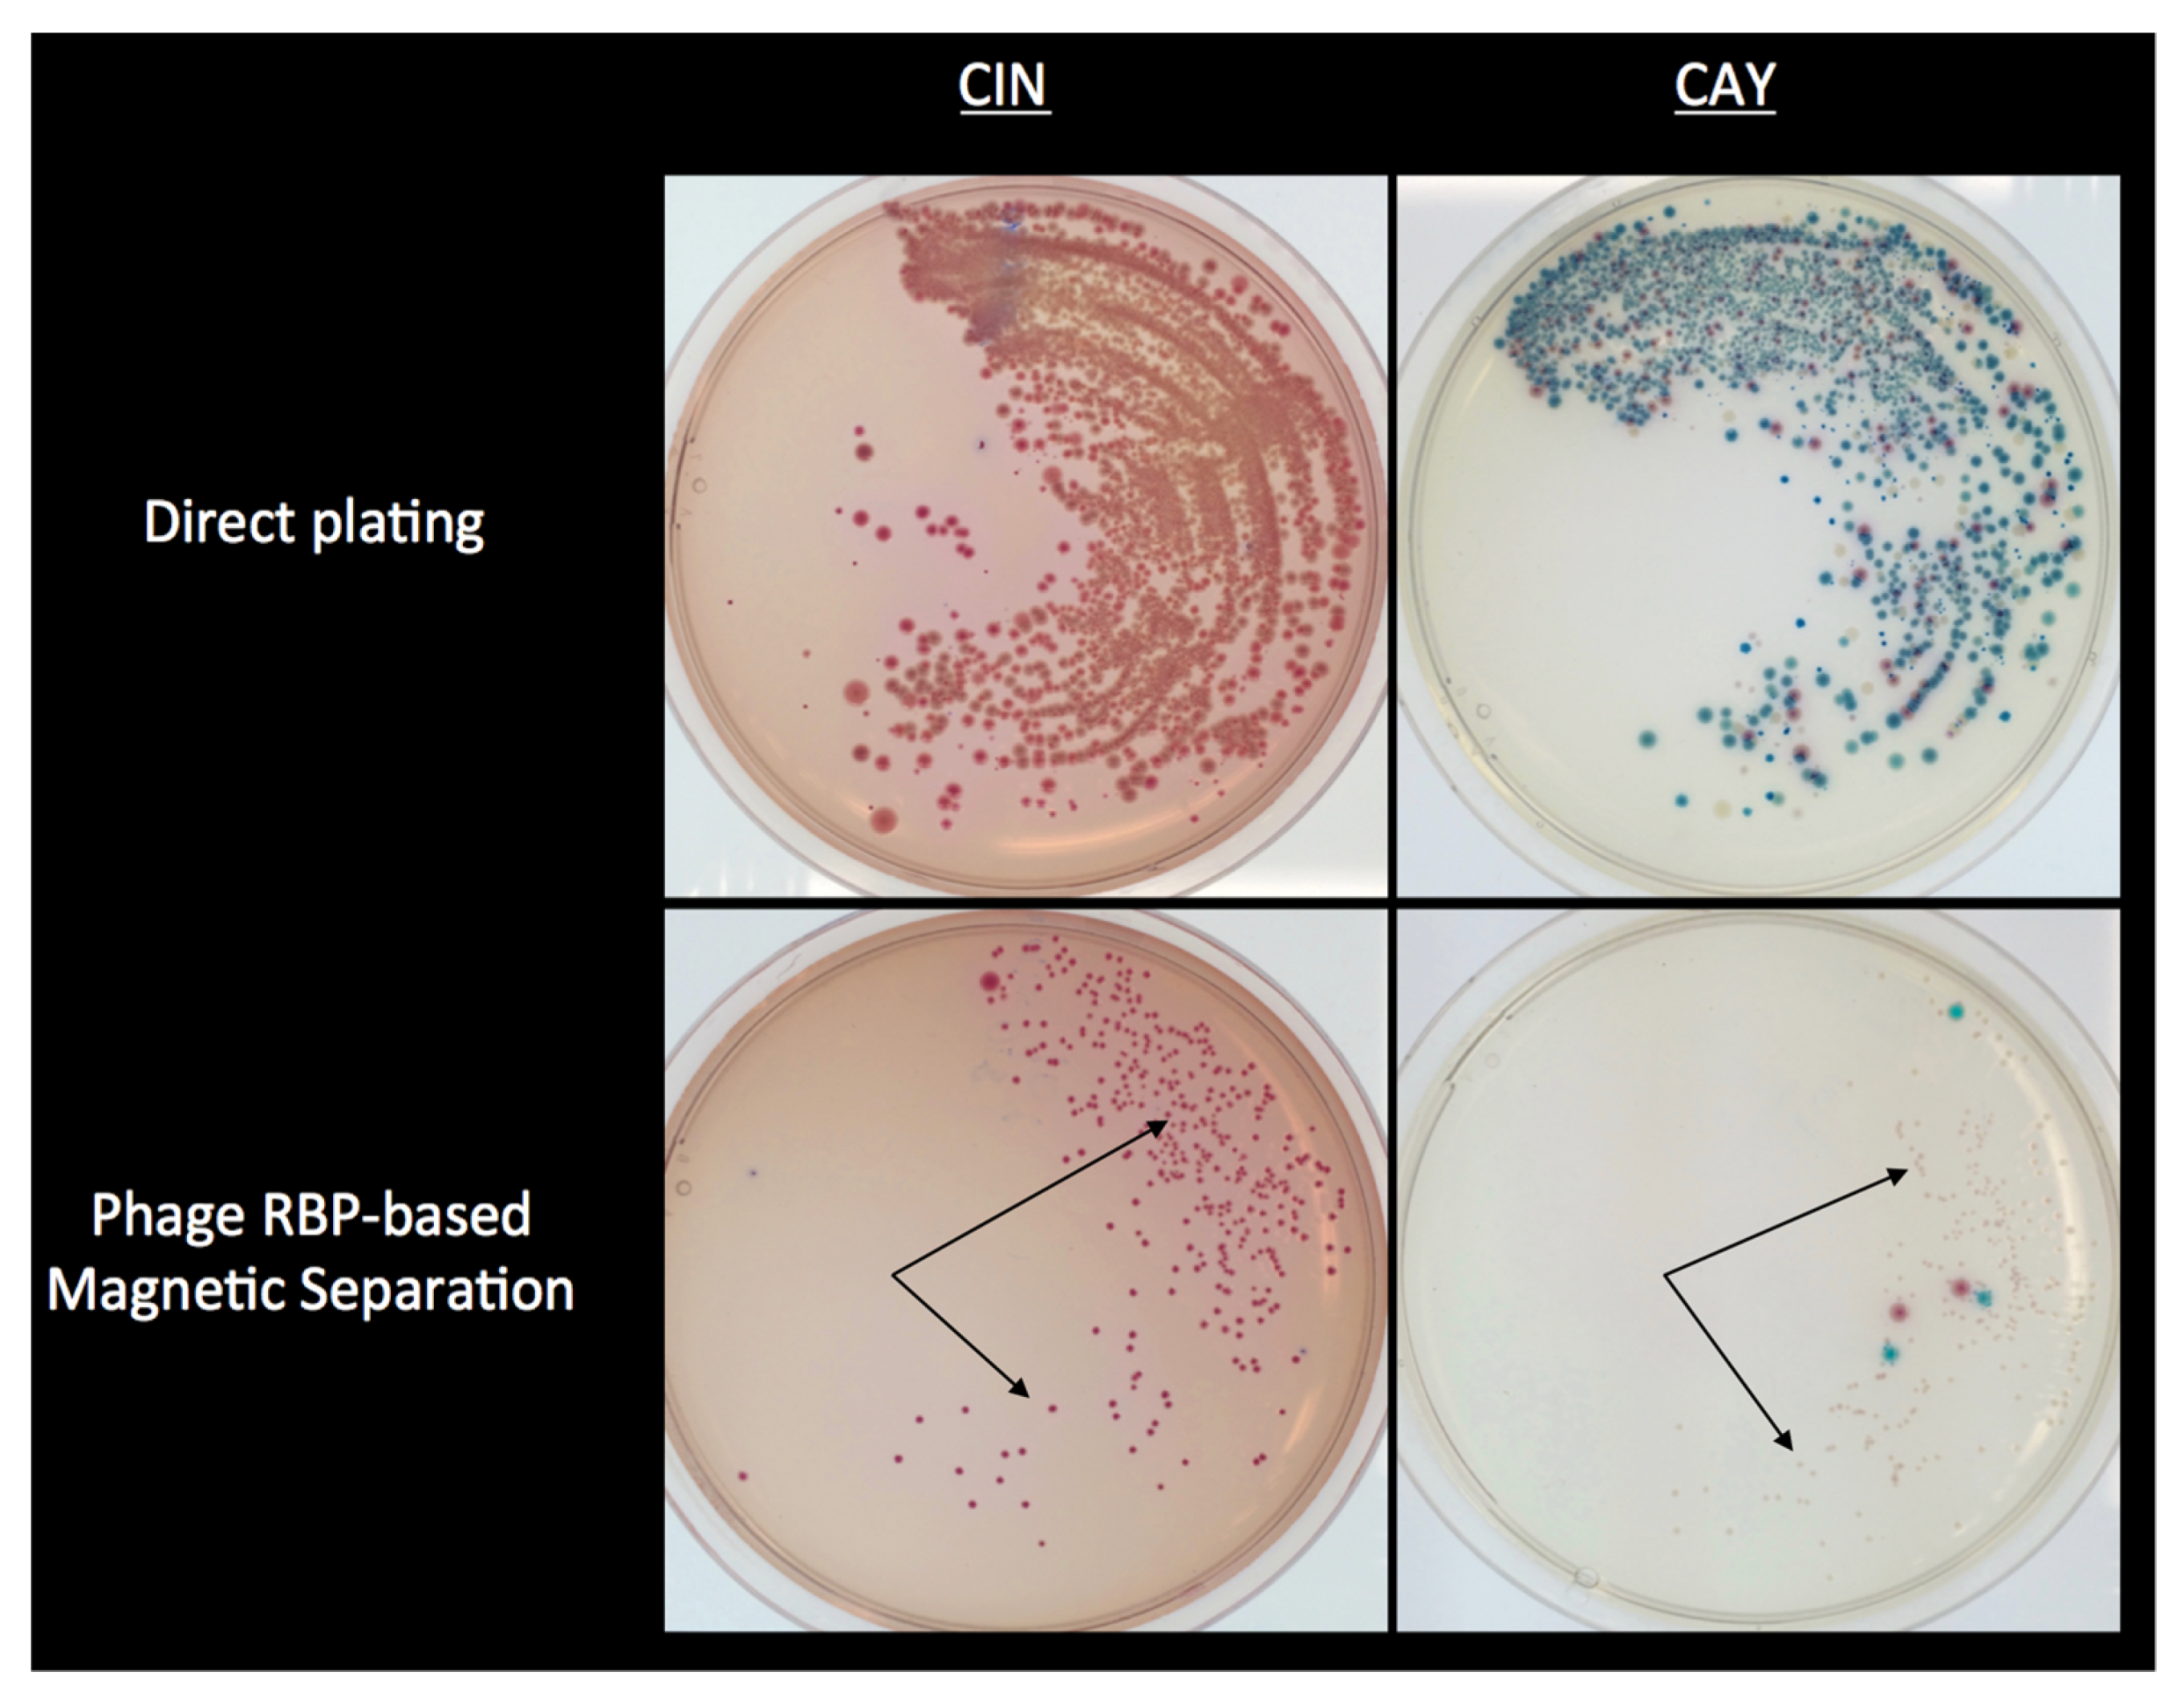
Viruses 11 01105 g002 Viruses 11 01105 g002

Yersinia Phages and Food Safety
Abstract
1. Introduction
2. Genus Yersinia and Diseases
3. Yersinia enterocolitica Bacteriophages
3.1. Podoviruses
3.2. Siphoviruses
3.3. Myoviruses
4. Applications of Yersinia Bacteriophages for Food Safety
4.1. Biocontrol of Y. enterocolitica
4.2. Phage RBPs for Use in Diagnostics
4.3. Agglutination Assays
4.4. Use of RBPs for the Selective Isolation of Y. enterocolitica from Foods
5. Perspectives
5.1. Diversity of Yersinia Enterocolitica Phages
5.2. Synthesis of RBPs
5.3. Acceptance of Phages for Biocontrol
Funding
Conflicts of Interest
References
- Hendrix, R.W. Bacteriophages: Evolution of the majority. Theor. Popul. Biol. 2002, 61, 471–480. [Google Scholar] [CrossRef] [PubMed]
- Bergh, O.; Borsheim, K.Y.; Bratbak, G.; Heldal, M. High abundance of viruses found in aquatic environments. Nature 1989, 340, 467–468. [Google Scholar] [CrossRef] [PubMed]
- Casjens, S. The diverse and dynamic structure of bacterial genomes. Annu. Rev. Genet. 1998, 32, 339–377. [Google Scholar] [CrossRef] [PubMed]
- Maura, D.; Debarbieux, L. Bacteriophages as twenty-first century antibacterial tools for food and medicine. Appl. Microbiol. Biotechnol. 2011, 90, 851–859. [Google Scholar] [CrossRef] [PubMed]
- Jun, J.W.; Kim, H.J.; Yun, S.K.; Chai, J.Y.; Park, S.C. Eating oysters without risk of vibriosis: Application of a bacteriophage against Vibrio parahaemolyticus in oysters. Int. J. Food Microbiol. 2014, 188, 31–35. [Google Scholar] [CrossRef] [PubMed]
- Centers for Disease Control and Prevention. Yersinia enterocolitica (Yersiniosis). 2016. Available online: https://www.cdc.gov/yersinia/ (accessed on 23 May 2019).
- McNally, A.; Thomson, N.R.; Reuter, S.; Wren, B.W. ‘Add, stir and reduce’: Yersinia spp. as model bacteria for pathogen evolution. Nat. Rev. Microbiol. 2016, 14, 177–190. [Google Scholar] [CrossRef] [PubMed]
- Bottone, E.J. Yersinia enterocolitica: Overview and epidemiologic correlates. Microbes Infect. 1999, 1, 323–333. [Google Scholar] [CrossRef]
- EFSA; ECDC. The European Union summary report on trends and sources of zoonoses, zoonotic agents and food-borne outbreaks in 2013. EFSA J. 2015, 13, 3991. [Google Scholar] [CrossRef]
- Jalava, K.; Hallanvuo, S.; Nakari, U.M.; Ruutu, P.; Kela, E.; Heinäsmäki, T.; Siitonen, A.; Nuorti, J.P. Multiple outbreaks of Yersinia pseudotuberculosis infections in Finland. J. Clin. Microbiol. 2004, 42, 2789–2791. [Google Scholar] [CrossRef]
- Baker, P.M.; Farmer, J.J.I. New bacteriophage typing system for Yersinia enterocolitica, Yersinia kristensenii, Yersinia frederiksenii, and Yersinia intermedia: Correlation with serotyping, biotyping, and antibiotic susceptibility. J. Clin. Microbiol. 1982, 15, 491–502. [Google Scholar]
- Bergan, T.; Norris, J.R. Bacteriophage typing of Yersinia enterocolitica. Methods Microbiol. 1978, 1, 225–236. [Google Scholar]
- Calvo, C.; Brault, J.; Alonso, J.M.; Mollaret, H.H. New waterborne bacteriophages active on Yersinia enterocolitica. Appl. Environ. Microbiol. 1981, 42, 35–38. [Google Scholar] [PubMed]
- Calvo, C.; Fernandez, A.; Bejar, V.; Cormenzana, A.R. Differenciation rapide des serovars O:3 et O:9 de Yersinia enterocolitica par certains bacteriophages. Ann. Inst. Pasteur/Microbiol. 1987, 138, 617–623. [Google Scholar] [CrossRef]
- Caprioli, T.; Drapeau, A.J.; Kasatiya, S. Yersinia enterocolitica: Serotypes and biotypes isolated from humans and the environment in Quebec, Canada. J. Clin. Microbiol. 1978, 8, 7–11. [Google Scholar] [PubMed]
- Kawaoka, Y.; Mitani, T.; Otsuki, K.; Tsubokura, M. Isolation and use of eight phages for typing Yersinia enterocolitica O3. J. Med. Microbiol. 1987, 23, 349–352. [Google Scholar] [CrossRef]
- Kawaoka, Y.; Otsuki, K.; Tsubokura, M. Characteristics of Yersinia enterocolitica bacteriophages. Zent. Bakteriol. Mikrobiol. Hyg. 1 Abt Orig. A 1982, 253, 102–109. [Google Scholar] [CrossRef]
- Nicolle, P.; Mollaret, H.; Hamon, Y.; Vieu, J.F. Étude lysogénique, bactériocinogénique et lysotypique de l’espèce Yersinia enterocolitica. Ann. L’Inst. Pasteur 1967, 112, 86–92. [Google Scholar]
- Nicolle, P.; Mollaret, H.; Brault, J. Current state of research on lysogeny and lysotyping of Yersinia enterocolitica. Arch. Roum. Pathol. Exp. Microbiol. 1969, 28, 1019–1027. [Google Scholar]
- Niléhn, B. Studies on Yersinia enterocolitica with special reference to bacterail diagnosis and occurrence in human acute enteric disease. Acta Pathol. Microbiol. Scand. 1969, 206, 1–48. [Google Scholar]
- Nilehn, B. Some aspects on phage typing of Yersinia enterocolitica. Acta Pathol. Microbiol. Scand. B Microbiol. Immunol. 1971, 79, 446–447. [Google Scholar]
- Tsubokura, M.; Otsuki, K.; Kawaoka, Y.; Fukushima, H. Lysogenicity and phage typing of Yersinia enterocolitica isolated in Japan. Jpn. J. Vet. Sci. 1982, 44, 433–437. [Google Scholar] [CrossRef] [PubMed]
- Darsavelidze, M.A.; Kapanadze Zh, S.; Chanishvili, T.G. Biological properties of bacteriophages, active to Yersinia enterocolitica. Zh. Mikrobiol. Epidemiol. I Immunobiol. 2004, 6, 10–13. [Google Scholar]
- Hertwig, S.; Popp, A.; Freytag, B.; Lurz, R.; Appel, B. Generalized transduction of small Yersinia enterocolitica plasmids. Appl. Environ. Microbiol. 1999, 65, 3862–3866. [Google Scholar] [PubMed]
- Kot, B.; Bukowski, K.; Jakubczak, A.; Kaczorek, I. The activity of chosen bacteriophages on Yersinia enterocolitica strains. Pol. J. Vet. Sci. 2002, 5, 47–50. [Google Scholar] [PubMed]
- Kudriakova, T.A.; Makedonova, L.D.; Kachkina, G.V.; Saiamov, S.R. Yersinia enterocolitica bacteriophages: Detection and identification. Klin. Lab. Diagn. 2010, 4, 43–45. [Google Scholar]
- Popp, A.; Hertwig, S.; Lurz, R.; Appel, B. Comparative study of temperate bacteriophages isolated from Yersinia. Syst. Appl. Microbiol. 2000, 23, 469–478. [Google Scholar] [CrossRef]
- Salem, M.; Skurnik, M. Genomic Characterization of Sixteen Yersinia enterocolitica-Infecting Podoviruses of Pig Origin. Viruses 2018, 10, 174. [Google Scholar] [CrossRef]
- Salem, M.; Virtanen, S.; Korkeala, H.; Skurnik, M. Isolation and characterization of Yersinia-specific bacteriophages from pig stools in Finland. J. Appl. Microbiol. 2015, 118, 599–608. [Google Scholar] [CrossRef]
- Pajunen, M.I.; Kiljunen, S.J.; Söderholm, M.-E.L.; Skurnik, M. Complete genomic sequence of the lytic bacteriophage fYeO3-12 of Yersinia enterocolitica serotype O:3. J. Bacteriol. 2001, 183, 1928–1937. [Google Scholar] [CrossRef]
- Leon-Velarde, C.G. The Application of Bacteriophage Host Recognition Binding Proteins for the Isolation of Yersinia enterocolitica in Foods. Ph.D. Thesis, University of Guelph, Guelph, ON, Canada, 2017. [Google Scholar]
- Leon-Velarde, C.G.; Kropinski, A.M.; Chen, S.; Abbasifar, A.; Griffiths, M.W.; Odumeru, J.A. Complete genome sequence of bacteriophage vB_YenP_AP5 which infects Yersinia enterocolitica of serotype O:3. Virol. J. 2014, 11, 188. [Google Scholar] [CrossRef]
- Liang, J.; Li, X.; Zha, T.; Chen, Y.; Hao, H.; Liu, C.; Duan, R.; Xiao, Y.; Su, M.; Wang, X.; et al. dTDP-rhamnosyl transferase RfbF, is a newfound receptor-related regulatory protein for phage phiYe-F10 specific for Yersinia enterocolitica serotype O:3. Sci. Rep. 2016, 6, 22905. [Google Scholar] [CrossRef] [PubMed]
- Biedzka-Sarek, M.; Jarva, H.; Hyytiäinen, H.; Meri, S.; Skurnik, M. Characterization of complement factor H binding to Yersinia enterocolitica serotype O:3. Infect. Immun. 2008, 76, 4100–4109. [Google Scholar] [CrossRef] [PubMed]
- Zhang, L.; Skurnik, M. Isolation of an R− M+ mutant of Yersinia enterocolitica serotype O:8 and its application in construction of rough mutants utilizing mini-Tn5 derivatives and lipopolysaccharide-specific phage. J. Bacteriol. 1994, 176, 1756–1760. [Google Scholar] [CrossRef] [PubMed][Green Version]
- Jun, J.W.; Park, S.C.; Wicklund, A.; Skurnik, M. Bacteriophages reduce Yersinia enterocolitica contamination of food and kitchenware. Int. J. Food Microbiol. 2018, 271, 33–47. [Google Scholar] [CrossRef]
- Pajunen, M.I.; Happonen, L.J.; Jun, J.W.; Malmström, J.; Nawaz, A.; Mattinen, L.; Skurnik, M. Genomic, functional and proteomic characterization of the T5-like bacteriophage ϕR2-01 infecting Yersinia enterocolitica. J. Virol. 2019. submitted. [Google Scholar]
- Hertwig, S.; Klein, I.; Hammerl, J.A.; Appel, B. Characterization of two conjugative Yersinia plasmids mobilizing pYV. Adv. Exp. Med. Biol. 2003, 529, 35–38. [Google Scholar]
- Hertwig, S.; Klein, I.; Lurz, R.; Lanka, E.; Appel, B. PY54, a linear plasmid prophage of Yersinia enterocolitica with covalently closed ends. Mol. Microbiol. 2003, 48, 989–1003. [Google Scholar] [CrossRef]
- Hertwig, S.; Klein, I.; Schmidt, V.; Beck, S.; Hammerl, J.A.; Appel, B. Sequence analysis of the genome of the temperate Yersinia enterocolitica phage PY54. J. Mol. Biol. 2003, 331, 605–622. [Google Scholar] [CrossRef]
- Kiljunen, S.; Hakala, K.; Pinta, E.; Huttunen, S.; Pluta, P.; Gador, A.; Lönnberg, H.; Skurnik, M. Yersiniophage fR1-37 is a tailed bacteriophage having a 270 kb DNA genome with thymidine replaced by deoxyuridine. Microbiology 2005, 151, 4093–4102. [Google Scholar] [CrossRef]
- Skurnik, M.; Hyytiäinen, H.J.; Happonen, L.J.; Kiljunen, S.; Datta, N.; Mattinen, L.; Williamson, K.; Kristo, P.; Szeliga, M.; Kalin-Mänttäri, L.; et al. Characterization of the genome, proteome, and structure of yersiniophage fR1-37. J. Virol. 2012, 86, 12625–12642. [Google Scholar] [CrossRef]
- Skurnik, M.; Venho, R.; Toivanen, P.; Al-Hendy, A. A novel locus of Yersinia enterocolitica serotype O:3 involved in lipopolysaccharide outer core biosynthesis. Mol. Microbiol. 1995, 17, 575–594. [Google Scholar] [CrossRef] [PubMed]
- Leon-Velarde, C.G.; Happonen, L.; Pajunen, M.; Leskinen, K.; Kropinski, A.M.; Mattinen, L.; Rajtor, M.; Zur, J.; Smith, D.; Chen, S.; et al. Yersinia enterocolitica-specific infection by bacteriophages TG1 and fR1-RT is dependent on temperature-regulated expression of the phage host receptor OmpF. Appl. Environ. Microbiol. 2016, 82, 5340–5353. [Google Scholar] [CrossRef] [PubMed]
- Hertwig, S.; Klein, I.; Appel, B. Properties of the temperate Yersinia enterocolitica bacteriophage PY54. Adv. Exp. Med. Biol. 2003, 529, 241–243. [Google Scholar] [PubMed]
- ECDC. Surveillance of Seven Priority Food- and Waterborne Diseases in the EU/EEA; ECDC: Solna Municipality, Sweden, 2015. [Google Scholar]
- Al-Hendy, A.; Toivanen, P.; Skurnik, M. Expression cloning of Yersinia enterocolitica O:3 rfb gene cluster in Escherichia coli K12. Microb. Pathog. 1991, 10, 47–59. [Google Scholar] [CrossRef]
- Pajunen, M.; Kiljunen, S.; Skurnik, M. Bacteriophage fYeO3-12, specific for Yersinia enterocolitica serotype O:3, is related to coliphages T3 and T7. J. Bacteriol. 2000, 182, 5114–5120. [Google Scholar] [CrossRef]
- Bruneteau, M.; Minka, S. Lipopolysaccharides of bacterial pathogens from the genus Yersinia: A mini-review. Biochimie 2003, 85, 145–152. [Google Scholar] [CrossRef]
- Gorshkova, R.P.; Kalmykova, E.N.; Isakov, V.V.; Ovodov, Y.S. Structural studies on O-specific polysaccharides of lipopolysaccharides from Yersinia enterocolitica serovars O:1,2a,3, O:2a,2b,3 and O:3. Eur. J. Biochem. 1985, 150, 527–531. [Google Scholar] [CrossRef]
- Hoffman, J.; Lindberg, B.; Brubaker, R.R. Structural studies of the O-specific side-chains of the lipopolysaccharide from Yersinia enterocolitica Ye 128. Carbohydr. Res. 1980, 78, 212–214. [Google Scholar] [CrossRef]
- Skurnik, M. My life with Yersinia. Adv. Exp. Med. Biol. 2007, 603, 44–73. [Google Scholar]
- Haggård-Ljungquist, E.; Halling, C.; Calendar, R. DNA sequences of the tail fiber genes of bacteriophage P2: Evidence for horizontal transfer of tail fiber genes among unrelated bacteriophages. J. Bacteriol. 1992, 174, 1462–1477. [Google Scholar] [CrossRef]
- Werts, C.; Michel, V.; Hofnung, M.; Charbit, A. Adsorption of bacteriophage lambda on the LamB protein of Escherichia coli K-12: Point mutations in gene J of lambda responsible for extended host range. J. Bacteriol. 1994, 176, 941–947. [Google Scholar] [CrossRef] [PubMed]
- Tam, W.; Pell, L.G.; Bona, D.; Tsai, A.; Dai, X.X.; Edwards, A.M.; Hendrix, R.W.; Maxwell, K.L.; Davidson, A.R. Tail tip proteins related to bacteriophage lambda gpL coordinate an iron-sulfur cluster. J. Mol. Biol. 2013, 425, 2450–2462. [Google Scholar] [CrossRef] [PubMed]
- Wang, J.; Hofnung, M.; Charbit, A. The C-terminal portion of the tail fiber protein of bacteriophage lambda is responsible for binding to LamB, its receptor at the surface of Escherichia coli K-12. J. Bacteriol. 2000, 182, 508–512. [Google Scholar] [CrossRef] [PubMed]
- Berkane, E.; Orlik, F.; Stegmeier, J.F.; Charbit, A.; Winterhalter, M.; Benz, R. Interaction of bacteriophage lambda with its cell surface receptor: An in vitro study of binding of the viral tail protein gpJ to LamB (Maltoporin). Biochemistry 2006, 45, 2708–2720. [Google Scholar] [CrossRef] [PubMed]
- Randall-Hazelbauer, L.; Schwartz, M. Isolation of the bacteriophage lambda receptor from Escherichia coli. J. Bacteriol. 1973, 116, 1436–1446. [Google Scholar] [PubMed]
- Effantin, G.; Boulanger, P.; Neumann, E.; Letellier, L.; Conway, J.F. Bacteriophage T5 structure reveals similarities with HK97 and T4 suggesting evolutionary relationships. J. Mol. Biol. 2006, 361, 993–1002. [Google Scholar] [CrossRef]
- Garcia-Doval, C.; Luque, D.; Caston, J.R.; Boulanger, P.; van Raaij, M.J. Crystallization of the C-terminal domain of the bacteriophage T5 L-shaped fibre. Acta Crystallogr. Sect. F Struct. Biol. Cryst. Commun. 2013, 69, 1363–1367. [Google Scholar] [CrossRef]
- Kaliman, A.V.; Kulshin, V.E.; Shlyapnikov, M.G.; Ksenzenko, V.N.; Kryukov, V.M. The nucleotide sequence of the bacteriophage T5 ltf gene. FEBS Lett. 1995, 366, 46–48. [Google Scholar] [CrossRef]
- Heller, K.J.; Bryniok, D. O antigen-dependent mutant of bacteriophage T5. J. Virol. 1984, 49, 20–25. [Google Scholar]
- Mondigler, M.; Holz, T.; Heller, K.J. Identification of the receptor-binding regions of pb5 proteins of bacteriophages T5 and BF23. Virology 1996, 219, 19–28. [Google Scholar] [CrossRef][Green Version]
- Schwudke, D.; Ergin, A.; Michael, K.; Volkmar, S.; Appel, B.; Knabner, D.; Konietzny, A.; Strauch, E. Broad-host-range Yersinia phage PY100: Genome sequence, proteome analysis of virions, and DNA packaging strategy. J. Bacteriol. 2008, 190, 332–342. [Google Scholar] [CrossRef] [PubMed]
- Orquera, S.; Golz, G.; Hertwig, S.; Hammerl, J.; Sparborth, D.; Joldic, A.; Alter, T. Control of Campylobacter spp. and Yersinia enterocolitica by virulent bacteriophages. J. Mol. Genet. Med. 2012, 6, 273–278. [Google Scholar] [CrossRef] [PubMed]
- Mesyanzhinov, V.V.; Robben, J.; Grymonprez, B.; Kostyuchenko, V.A.; Bourkaltseva, M.V.; Sykilinda, N.N.; Krylov, V.N.; Volckaert, G. The genome of bacteriophage fKZ of Pseudomonas aeruginosa. J. Mol. Biol. 2002, 317, 1–19. [Google Scholar] [CrossRef] [PubMed]
- Pajunen, M.I.; Molineux, I.J.; Skurnik, M. Yersiniophages. In The Genus Yersinia: Entering the Functional Genomic Era; Skurnik, M., Granfors, K., Bengoechea, J.A., Eds.; Kluwer Academic: Dordrecht, The Netherlands; Plenum Publishers: New York, NY, USA, 2003; pp. 233–240. [Google Scholar]
- Al-Hendy, A.; Toivanen, P.; Skurnik, M. Lipopolysaccharide O side chain of Yersinia enterocolitica O:3 is an essential virulence factor in an orally infected murine model. Infect. Immun. 1992, 60, 870–875. [Google Scholar]
- Beczala, A.; Ovchinnikova, O.G.; Datta, N.; Mattinen, L.; Knapska, K.; Radziejewska-Lebrecht, J.; Holst, O.; Skurnik, M. Structure and genetic basis of Yersinia similis serotype O:9 O-specific polysaccharide. Innate Immun. 2015, 21, 3–16. [Google Scholar] [CrossRef]
- Yu, S.L.; Ko, K.L.; Chen, C.S.; Chang, Y.C.; Syu, W.J. Characterization of the distal tail fiber locus and determination of the receptor for phage AR1, which specifically infects Escherichia coli O157:H7. J. Bacteriol. 2000, 182, 5962–5968. [Google Scholar] [CrossRef]
- Qasim, M.S. Evaluation of Receptor-Binding Protein of Bacteriophage ϕR1-37. Master’s Thesis, University of Helsinki, Helsinki, Finland, 2018. [Google Scholar]
- Adams, M.J.; Lefkowitz, E.J.; King, A.M.; Harrach, B.; Harrison, R.L.; Knowles, N.J.; Kropinski, A.M.; Krupovic, M.; Kuhn, J.H.; Mushegian, A.R.; et al. Ratification vote on taxonomic proposals to the International Committee on Taxonomy of Viruses (2016). Arch. Virol. 2016, 161, 2921–2949. [Google Scholar] [CrossRef]
- Sulakvelidze, A. Safety by nature: Potential bacteriophage applications. Microbe Mag. 2011, 6, 122–126. [Google Scholar] [CrossRef]
- Endersen, L.; O’Mahony, J.; Hill, C.; Ross, R.P.; McAuliffe, O.; Coffey, A. Phage therapy in the food industry. Annu. Rev. Food Sci. Technol. 2014, 5, 327–349. [Google Scholar] [CrossRef]
- Hagens, S.; Loessner, M.J. Bacteriophage for biocontrol of foodborne pathogens: Calculations and considerations. Curr. Pharm. Biotechnol. 2010, 11, 58–68. [Google Scholar] [CrossRef]
- Fernandez, L.; Gutierrez, D.; Garcia, P.; Rodriguez, A. The Perfect Bacteriophage for Therapeutic Applications—A Quick Guide. Antibiotics 2019, 8, 126. [Google Scholar] [CrossRef] [PubMed]
- Goodridge, L.D.; Bisha, B. Phage-based biocontrol strategies to reduce foodborne pathogens in foods. Bacteriophage 2011, 1, 130–137. [Google Scholar] [CrossRef] [PubMed]
- Sommer, J.; Trautner, C.; Witte, A.K.; Fister, S.; Schoder, D.; Rossmanith, P.; Mester, P.J. Don’t Shut the Stable Door after the Phage Has Bolted-The Importance of Bacteriophage Inactivation in Food Environments. Viruses 2019, 11, 468. [Google Scholar] [CrossRef] [PubMed]
- Kazi, M.; Annapure, U.S. Bacteriophage biocontrol of foodborne pathogens. J. Food Sci. Technol. 2016, 53, 1355–1362. [Google Scholar] [CrossRef] [PubMed]
- Bennett, A.R.; Davids, F.G.C.; Vlahodimou, S.; Banks, J.G.; Betts, R.P. The use of bacteriophage-based systems for the separation and concentration of Salmonella. J. Appl. Microbiol. 1997, 83, 259–265. [Google Scholar] [CrossRef] [PubMed]
- Blasco, R.; Murphy, M.J.; Sanders, M.F.; Squirrell, D.J. Specific assays for bacteria using phage mediated release of adenylate kinase. J. Appl. Microbiol. 1998, 84, 661–666. [Google Scholar] [CrossRef]
- Favrin, S.J.; Jassim, S.A.; Griffiths, M.W. Development and optimization of a novel immunomagnetic separation-bacteriophage assay for detection of Salmonella enterica serovar Enteritidis in broth. Appl. Environ. Microbiol. 2001, 67, 217–224. [Google Scholar] [CrossRef]
- Favrin, S.J.; Jassim, S.A.; Griffiths, M.W. Application of a novel immunomagnetic separation-bacteriophage assay for the detection of Salmonella enteritidis and Escherichia coli O157:H7 in food. Int. J. Food Microbiol. 2003, 85, 63–71. [Google Scholar] [CrossRef]
- Galikowska, E.; Kunikowska, D.; Tokarska-Pietrzak, E.; Dziadziuszko, H.; Los, J.M.; Golec, P.; Wegrzyn, G.; Los, M. Specific detection of Salmonella enterica and Escherichia coli strains by using ELISA with bacteriophages as recognition agents. Eur. J. Clin. Microbiol. Infect. Dis. 2011, 30, 1067–1073. [Google Scholar] [CrossRef]
- Jiang, L.; Jiang, Q.; Huang, K.; Zhang, C.; Tang, T. Rapid detection of Salmonella in food by using fluorescently labeled phage O-I. Acta Microbiol. Sin. 2009, 49, 372–377. [Google Scholar]
- Kuhn, J.; Suissa, M.; Wyse, J.; Cohen, I.; Weiser, I.; Reznick, S.; Lubinsky-Mink, S.; Stewart, G.; Ulitzur, S. Detection of bacteria using foreign DNA: The development of a bacteriophage reagent for Salmonella. Int. J. Food Microbiol. 2002, 74, 229–238. [Google Scholar] [CrossRef]
- Minikh, O.; Tolba, M.; Brovko, L.Y.; Griffiths, M.W. Bacteriophage-based biosorbents coupled with bioluminescent ATP assay for rapid concentration and detection of Escherichia coli. J. Microbiol. Methods 2010, 82, 177–183. [Google Scholar] [CrossRef] [PubMed]
- Thouand, G.; Vachon, P.; Liu, S.; Dayre, M.; Griffiths, M.W. Optimization and validation of a simple method using P22: LuxAB bacteriophage for rapid detection of Salmonella enterica serotypes A, B, and D in poultry samples. J. Food Prot. 2008, 71, 380–385. [Google Scholar] [CrossRef] [PubMed]
- Tolba, M.; Minikh, O.; Brovko, L.Y.; Evoy, S.; Griffiths, M.W. Oriented immobilization of bacteriophages for biosensor applications. Appl. Environ. Microbiol. 2010, 76, 528–535. [Google Scholar] [CrossRef] [PubMed]
- Wolber, P.K.; Green, R.L. Detection of bacteria by transduction of ice nucleation genes. Trends Biotechnol. 1990, 8, 276–279. [Google Scholar] [CrossRef]
- Wu, Y.; Brovko, L.; Griffiths, M.W. Influence of phage population on the phage-mediated bioluminescent adenylate kinase (AK) assay for detection of bacteria. Lett. Appl. Microbiol. 2001, 33, 311–315. [Google Scholar] [CrossRef]
- Korndorfer, I.P.; Danzer, J.; Schmelcher, M.; Zimmer, M.; Skerra, A.; Loessner, M.J. The crystal structure of the bacteriophage PSA endolysin reveals a unique fold responsible for specific recognition of Listeria cell walls. J. Mol. Biol. 2006, 364, 678–689. [Google Scholar] [CrossRef]
- Kretzer, J.W.; Lehmann, R.; Schmelcher, M.; Banz, M.; Kim, K.P.; Korn, C.; Loessner, M.J. Use of high-affinity cell wall-binding domains of bacteriophage endolysins for immobilization and separation of bacterial cells. Appl. Environ. Microbiol. 2007, 73, 1992–2000. [Google Scholar] [CrossRef]
- Loessner, M.J.; Kramer, K.; Ebel, F.; Scherer, S. C-terminal domains of Listeria monocytogenes bacteriophage murein hydrolases determine specific recognition and high-affinity binding to bacterial cell wall carbohydrates. Mol. Microbiol. 2002, 44, 335–349. [Google Scholar] [CrossRef]
- Marti, R.; Zurfluh, K.; Hagens, S.; Pianezzi, J.; Klumpp, J.; Loessner, M.J. Long tail fibres of the novel broad-host-range T-even bacteriophage S16 specifically recognize Salmonella OmpC. Mol. Microbiol. 2013, 87, 818–834. [Google Scholar] [CrossRef]
- Singh, A.; Arya, S.K.; Glass, N.; Hanifi-Moghaddam, P.; Naidoo, R.; Szymanski, C.M.; Tanha, J.; Evoy, S. Bacteriophage tailspike proteins as molecular probes for sensitive and selective bacterial detection. Biosens. Bioelectron. 2010, 26, 131–138. [Google Scholar] [CrossRef] [PubMed]
- Singh, A.; Arutyunov, D.; McDermott, M.T.; Szymanski, C.M.; Evoy, S. Specific detection of Campylobacter jejuni using the bacteriophage NCTC 12673 receptor binding protein as a probe. Analyst 2011, 136, 4780–4786. [Google Scholar] [CrossRef] [PubMed]
- Waseh, S.; Hanifi-Moghaddam, P.; Coleman, R.; Masotti, M.; Ryan, S.; Foss, M.; MacKenzie, R.; Henry, M.; Szymanski, C.M.; Tanha, J. Orally administered P22 phage tailspike protein reduces Salmonella colonization in chickens: Prospects of a novel therapy against bacterial infections. PLoS ONE 2010, 5, e13904. [Google Scholar] [CrossRef] [PubMed]
- Kropinski, A.M.; Arutyunov, D.; Foss, M.; Cunningham, A.; Ding, W.; Singh, A.; Pavlov, A.R.; Henry, M.; Evoy, S.; Kelly, J.; et al. Genome and proteome of Campylobacter jejuni bacteriophage NCTC 12673. Appl. Environ. Microbiol. 2011, 77, 8265–8271. [Google Scholar] [CrossRef] [PubMed]
- Fredriksson-Ahomaa, M.; Korkeala, H. Low occurrence of pathogenic Yersinia enterocolitica in clinical, food, and environmental samples: A methodological problem. Clin. Microbiol. Rev. 2003, 16, 220–229. [Google Scholar] [CrossRef] [PubMed]
- Cocolin, L.; Comi, G. Use of a culture-independent molecular method to study the ecology of Yersinia spp. in food. Int. J. Food Microbiol. 2005, 105, 71–82. [Google Scholar] [CrossRef]
- Balakrishna, K.; Murali, H.S.; Batra, H.V. Cloning, expression and characterization of attachment-invasion locus protein (Ail) of Yersinia enterocolitica and its utilization in rapid detection by immunoassays. Lett. Appl. Microbiol. 2010, 50, 131–137. [Google Scholar] [CrossRef]
- Schwarzer, D.; Stummeyer, K.; Gerardy-Schahn, R.; Muhlenhoff, M. Characterization of a novel intramolecular chaperone domain conserved in endosialidases and other bacteriophage tail spike and fiber proteins. J. Biol. Chem. 2007, 282, 2821–2831. [Google Scholar] [CrossRef]
- Khamjing, W.; Khongchareonporn, N.; Rengpipat, S. Detection by using monoclonal antibodies of Yersinia enterocolitica in artificially-contaminated pork. Microbiol. Immunol. 2011, 55, 605–615. [Google Scholar] [CrossRef]
- Nesbakken, T.; Kapperud, G.; Dommarsnes, K.; Skurnik, M.; Hornes, E. Comparative study of a DNA hybridization method and two isolation procedures for detection of Yersinia enterocolitica O:3 in naturally contaminated pork products. Appl. Environ. Microbiol. 1991, 57, 389–394. [Google Scholar]
- Kaneko, S.; Ishizaki, N.; Kokubo, Y. Detection of pathogenic Yersinia enterocolitica and Yersinia pseudotuberculosis from pork using the polymerase chain reaction. In Yersiniosis: Present and Future; Ravagnan, G., Chiesa, C., Eds.; Karger: Basel, Switzerland, 1995; pp. 153–155. [Google Scholar]
- Lantz, P.G.; Knutsson, R.; Blixt, Y.; Al Soud, W.A.; Borch, E.; Rådström, P. Detection of pathogenic Yersinia enterocolitica in enrichment media and pork by a multiplex PCR: A study of sample preparation and PCR-inhibitory components. Int. J. Food Microbiol. 1998, 45, 93–105. [Google Scholar] [CrossRef]
- Garcia-Doval, C.; van Raaij, M.J. Structure of the receptor-binding carboxy-terminal domain of bacteriophage T7 tail fibers. Proc. Natl. Acad. Sci. USA 2012, 109, 9390–9395. [Google Scholar] [CrossRef] [PubMed]
- Lambertz, S.T.; Nilsson, C.; Hallanvuo, S.; Lindblad, M. Real-time PCR method for detection of pathogenic Yersinia enterocolitica in food. Appl. Environ. Microbiol. 2008, 74, 6060–6067. [Google Scholar] [CrossRef] [PubMed]
- Bang, J.; Beuchat, L.R.; Gu, M.B.; Chang, H.I.; Ryu, J.H. Identification of Yersinia enterocolitica using a random genomic DNA microarray chip. Lett. Appl. Microbiol. 2010, 51, 665–670. [Google Scholar] [CrossRef] [PubMed]
- Gao, H.; Lei, Z.; Jia, J.; Wang, S.; Chen, Y.; Sun, M.; Liang, C. Application of loop-mediated isothermal amplification for detection of Yersinia enterocolitica in pork meat. J. Microbiol. Methods 2009, 77, 198–201. [Google Scholar] [CrossRef] [PubMed]
- Boyapalle, S.; Wesley, I.V.; Hurd, H.S.; Reddy, P.G. Comparison of culture, multiplex, and 5’ nuclease polymerase chain reaction assays for the rapid detection of Yersinia enterocolitica in swine and pork products. J. Food Prot. 2001, 64, 1352–1361. [Google Scholar] [CrossRef] [PubMed][Green Version]
- Johannessen, G.S.; Kapperud, G.; Kruse, H. Occurrence of pathogenic Yersinia enterocolitica in Norwegian pork products determined by a PCR method and a traditional culturing method. Int. J. Food Microbiol. 2000, 54, 75–80. [Google Scholar] [CrossRef]
- Arnold, T.; Neubauer, H.; Nikolaou, K.; Roesler, U.; Hensel, A. Identification of Yersinia enterocolitica in minced meat: A comparative analysis of API 20E, Yersinia identification kit and a 16S rRNA-based PCR method. J. Vet. Med. B Infect. Dis. Vet. Public Health 2004, 51, 23–27. [Google Scholar] [CrossRef]
- De Boer, E. Isolation of Yersinia enterocolitica from foods. Int. J. Food Microbiol. 1992, 17, 75–84. [Google Scholar] [CrossRef]
- Schiemann, D.A.; Olson, S.A. Antagonism by gram-negative bacteria to growth of Yersinia enterocolitica in mixed cultures. Appl. Environm. Microbiol. 1984, 48, 539–544. [Google Scholar]
- Schiemann, D.A. Synthesis of a selective agar medium for Yersinia enterocolitica. Can. J. Microbiol. 1979, 25, 1298–1304. [Google Scholar] [CrossRef] [PubMed]
- Fukushima, H. New selective agar medium for isolation of virulent Yersinia enterocolitica. J. Clin. Microbiol. 1987, 25, 1068–1073. [Google Scholar] [PubMed]
- Kwaga, J.; Iversen, J.O. In Vitro Antimicrobial Susceptibles of Yersinia enterocolitica and Related Species Isolated from Slaughtered Pigs and Pork Products. Antimicrob. Agents Chemother. 1990, 34, 2423–2425. [Google Scholar] [CrossRef] [PubMed]
- Wauters, G.; Goossens, V.; Janssens, M.; Vandepitte, J. New enrichment method for isolation of pathogenic Yersinia enterocolitica serogroup O:3 from pork. Appl. Environm. Microbiol. 1988, 54, 851–854. [Google Scholar]
- Stevens, K.A.; Jaykus, L.A. Bacterial separation and concentration from complex sample matrices: A review. Crit. Rev. Microbiol. 2004, 30, 7–24. [Google Scholar] [CrossRef]
- Ueda, S. Simultaneous detection of some Yersinia enterocolitica serovars from food and human samples by PCR after IMS-plating. Biocontrol Sci. 2005, 10, 111–115. [Google Scholar] [CrossRef]
- Ueda, S.; Maruyama, T.; Kuwabara, A. A method combined immunomagnetic separation followed by plating and polymerase chain reaction assay for the detection of pathogenic Yersinia enterocolitica from food and fecal samples. Biocontrol Sci. 2003, 8, 77–86. [Google Scholar] [CrossRef][Green Version]
- Rasmussen, H.N.; Rasmussen, O.F.; Christensen, H.; Olsen, J.E. Detection of Yersinia enterocolitica O:3 in faecal samples and tonsil swabs from pigs using IMS and PCR. J. Appl. Bact. 1995, 78, 563–568. [Google Scholar] [CrossRef]
- Kapperud, G.; Vardund, T.; Skjerve, E.; Hornes, E.; Michaelsen, T.E. Detection of pathogenic Yersinia enterocolitica in foods and water by immunomagnetic separation, nested polymerase chain reactions, and colorimetric detection of amplified DNA. Appl. Environ. Microbiol. 1993, 59, 2938–2944. [Google Scholar]
- Estrada, C.S.; Velazquez Ldel, C.; Favier, G.I.; Genaro, M.S.; Escudero, M.E. Detection of Yersinia spp. in meat products by enrichment culture, immunomagnetic separation and nested PCR. Food Microbiol. 2012, 30, 157–163. [Google Scholar] [CrossRef]
- Koujitani, E.; Horisaka, T.; Nomura, Y.; Hara-Kudo, Y.; Okatani, A.T.; Iwata, T.; Kumagai, S.; Hayashidani, H. Immuno-magnetic separation and agar layer methods for the isolation of freeze-injured Yersinia enterocolitica O:8 from water. J. Vet. Med. Sci. 2006, 68, 195–199. [Google Scholar] [CrossRef] [PubMed]
- Wang, W.; Singh, S.; Zeng, D.L.; King, K.; Nema, S. Antibody structure, instability, and formulation. J. Pharm. Sci. 2007, 96, 1–26. [Google Scholar] [CrossRef] [PubMed]
- Laporte, J.; Savin, C.; Lamourette, P.; Devilliers, K.; Volland, H.; Carniel, E.; Creminon, C.; Simon, S. Fast and sensitive detection of enteropathogenic Yersinia by immunoassays. J. Clin. Microbiol. 2015, 53, 146–159. [Google Scholar] [CrossRef] [PubMed]
- Kooi, C.; Sokol, P.A. Characterization of monoclonal antibodies to Yersinia enterocolitica iron-regulated proteins. Can. J. Microb. 1995, 41, 562–571. [Google Scholar] [CrossRef] [PubMed]
- Sihvonen, L.M.; Jalkanen, K.; Huovinen, E.; Toivonen, S.; Corander, J.; Kuusi, M.; Skurnik, M.; Siitonen, A.; Haukka, K. Clinical isolates of Yersinia enterocolitica Biotype 1A represent two phylogenetic lineages with differing pathogenicity-related properties. BMC Microbiol. 2012, 12, 208. [Google Scholar] [CrossRef] [PubMed]
- Tennant, S.M.; Grant, T.H.; Robins-Browne, R.M. Pathogenicity of Yersinia enterocolitica biotype 1A. FEMS Immunol. Med. Microbiol. 2003, 38, 127–137. [Google Scholar] [CrossRef]
- Sihvonen, L.M.; Haukka, K.; Kuusi, M.; Virtanen, M.J.; Siitonen, A.; YE Study Group. Yersinia enterocolitica and Y. enterocolitica-like species in clinical stool specimens of humans: Identification and prevalence of bio/serotypes in Finland. Eur. J. Clin. Microbiol. Infect. Dis. 2009, 28, 757–765. [Google Scholar] [CrossRef]
- Denis, M.; Houard, E.; Labbe, A.; Fondrevez, M.; Salvat, G. A Selective Chromogenic Plate, YECA, for the Detection of Pathogenic Yersinia enterocolitica: Specificity, Sensitivity, and Capacity to Detect Pathogenic Y. enterocolitica from Pig Tonsils. J. Pathog. 2011, 2011, 296275. [Google Scholar] [CrossRef]
- Karhukorpi, J.; Päivänurmi, M. Differentiation of Yersinia enterocolitica biotype 1A from pathogenic Yersinia enterocolitica biotypes by detection of beta-glucosidase activity: Comparison of two chromogenic culture media and Vitek2. J. Med. Microbiol. 2014, 63, 34–37. [Google Scholar] [CrossRef]
- Renaud, N.; Lecci, L.; Courcol, R.J.; Simonet, M.; Gaillot, O. CHROMagar Yersinia, a new chromogenic agar for screening of potentially pathogenic Yersinia enterocolitica isolates in stools. J. Clin. Microbiol. 2013, 51, 1184–1187. [Google Scholar] [CrossRef]
- Serwer, P.; Hayes, S.J.; Thomas, J.A.; Hardies, S.C. Propagating the missing bacteriophages: A large bacteriophage in a new class. Virol. J. 2007, 4, 21. [Google Scholar] [CrossRef] [PubMed]
- Bartual, S.G.; Garcia-Doval, C.; Alonso, J.; Schoehn, G.; van Raaij, M.J. Two-chaperone assisted soluble expression and purification of the bacteriophage T4 long tail fibre protein gp37. Protein Expr. Purif. 2010, 70, 116–121. [Google Scholar] [CrossRef] [PubMed]
- Burda, M.R.; Miller, S. Folding of coliphage T4 short tail fiber in vitro. Analysing the role of a bacteriophage-encoded chaperone. Eur. J. Biochem. 1999, 265, 771–778. [Google Scholar] [CrossRef] [PubMed]
- Hashemolhosseini, S.; Stierhof, Y.D.; Hindennach, I.; Henning, U. Characterization of the helper proteins for the assembly of tail fibers of coliphages T4 and lambda. J. Bacteriol. 1996, 178, 6258–6265. [Google Scholar] [CrossRef] [PubMed]
- Herrmann, R.; Wood, W.B. Assembly of bacteriophage T4 tail fibers: Identification and characterization of the nonstructural protein gp57. Mol. Gen. Genet. 1981, 184, 125–132. [Google Scholar] [CrossRef] [PubMed]
- Matsui, T.; Griniuviene, B.; Goldberg, E.; Tsugita, A.; Tanaka, N.; Arisaka, F. Isolation and characterization of a molecular chaperone, gp57A, of bacteriophage T4. J. Bacteriol. 1997, 179, 1846–1851. [Google Scholar] [CrossRef] [PubMed]
- Leiman, P.G.; Arisaka, F.; van Raaij, M.J.; Kostyuchenko, V.A.; Aksyuk, A.A.; Kanamaru, S.; Rossmann, M.G. Morphogenesis of the T4 tail and tail fibers. Virol. J. 2010, 7, 355. [Google Scholar] [CrossRef]
- Danner, M.; Fuchs, A.; Miller, S.; Seckler, R. Folding and assembly of phage P22 tailspike endorhamnosidase lacking the N-terminal, head-binding domain. Eur. J. Biochem. 1993, 215, 653–661. [Google Scholar] [CrossRef]
- Muhlenhoff, M.; Stummeyer, K.; Grove, M.; Sauerborn, M.; Gerardy-Schahn, R. Proteolytic processing and oligomerization of bacteriophage-derived endosialidases. J. Biol. Chem. 2003, 278, 12634–12644. [Google Scholar] [CrossRef]
- Schulz, E.C.; Schwarzer, D.; Frank, M.; Stummeyer, K.; Muhlenhoff, M.; Dickmanns, A.; Gerardy-Schahn, R.; Ficner, R. Structural basis for the recognition and cleavage of polysialic acid by the bacteriophage K1F tailspike protein EndoNF. J. Mol. Biol. 2010, 397, 341–351. [Google Scholar] [CrossRef]
- Xiang, Y.; Leiman, P.G.; Li, L.; Grimes, S.; Anderson, D.L.; Rossmann, M.G. Crystallographic insights into the autocatalytic assembly mechanism of a bacteriophage tail spike. Mol. Cell 2009, 34, 375–386. [Google Scholar] [CrossRef] [PubMed]
- Thompson, J.E.; Pourhossein, M.; Waterhouse, A.; Hudson, T.; Goldrick, M.; Derrick, J.P.; Roberts, I.S. The K5 lyase KflA combines a viral tail spike structure with a bacterial polysaccharide lyase mechanism. J. Biol. Chem. 2010, 285, 23963–23969. [Google Scholar] [CrossRef] [PubMed]
- Schulz, E.C.; Dickmanns, A.; Urlaub, H.; Schmitt, A.; Muhlenhoff, M.; Stummeyer, K.; Schwarzer, D.; Gerardy-Schahn, R.; Ficner, R. Crystal structure of an intramolecular chaperone mediating triple-beta-helix folding. Nat. Struct. Mol. Biol. 2010, 17, 210–215. [Google Scholar] [CrossRef] [PubMed]
- Leiman, P.G.; Battisti, A.J.; Bowman, V.D.; Stummeyer, K.; Muhlenhoff, M.; Gerardy-Schahn, R.; Scholl, D.; Molineux, I.J. The structures of bacteriophages K1E and K1-5 explain processive degradation of polysaccharide capsules and evolution of new host specificities. J. Mol. Biol. 2007, 371, 836–849. [Google Scholar] [CrossRef]
- Bartual, S.G.; Otero, J.M.; Garcia-Doval, C.; Llamas-Saiz, A.L.; Kahn, R.; Fox, G.C.; van Raaij, M.J. Structure of the bacteriophage T4 long tail fiber receptor-binding tip. Proc. Natl. Acad. Sci. USA 2010, 107, 20287–20292. [Google Scholar] [CrossRef]
- Panchenko, A.R.; Luthey-Schulten, Z.; Cole, R.; Wolynes, P.G. The foldon universe: A survey of structural similarity and self-recognition of independently folding units. J. Mol. Biol. 1997, 272, 95–105. [Google Scholar] [CrossRef]
- Maity, H.; Maity, M.; Krishna, M.M.; Mayne, L.; Englander, S.W. Protein folding: The stepwise assembly of foldon units. Proc. Natl. Acad. Sci. USA 2005, 102, 4741–4746. [Google Scholar] [CrossRef]
- Miroshnikov, K.A.; Marusich, E.I.; Cerritelli, M.E.; Cheng, N.; Hyde, C.C.; Steven, A.C.; Mesyanzhinov, V.V. Engineering trimeric fibrous proteins based on bacteriophage T4 adhesins. Protein Eng. 1998, 11, 329–332. [Google Scholar] [CrossRef]
- Miroshnikov, K.A.; Sernova, N.V.; Shneider, M.M.; Mesyanzhinov, V.V. Transformation of a fragment of beta-structural bacteriophage T4 adhesin to stable alpha-helical trimer. Biochemistry 2000, 65, 1346–1351. [Google Scholar]
- Tao, Y.; Strelkov, S.V.; Mesyanzhinov, V.V.; Rossmann, M.G. Structure of bacteriophage T4 fibritin: A segmented coiled coil and the role of the C-terminal domain. Structure 1997, 5, 789–798. [Google Scholar] [CrossRef]
- Chuprov-Netochin, R.N.; Faizullina, N.M.; Sykilinda, N.N.; Simakova, M.N.; Mesianzhinov, V.V.; Miroshnikov, K.A. The beta-helical domain of bacteriophage T4 controls the folding of the fragment of long tail fibers in a chimeric protein. Russ. J. Bioorg. Chem. 2010, 36, 172–178. [Google Scholar] [CrossRef] [PubMed]
- Kanamaru, S.; Leiman, P.G.; Kostyuchenko, V.A.; Chipman, P.R.; Mesyanzhinov, V.V.; Arisaka, F.; Rossmann, M.G. Structure of the cell-puncturing device of bacteriophage T4. Nature 2002, 415, 553–557. [Google Scholar] [CrossRef] [PubMed]
- Nakagawa, H.; Arisaka, F.; Ishii, S. Isolation and characterization of the bacteriophage T4 tail-associated lysozyme. J. Virol. 1985, 54, 460–466. [Google Scholar] [PubMed]
- Mesyanzhinov, V.V.; Leiman, P.G.; Kostyuchenko, V.A.; Kurochkina, L.P.; Miroshnikov, K.A.; Sykilinda, N.N.; Shneider, M.M. Molecular architecture of bacteriophage T4. Biochemistry 2004, 69, 1190–1202. [Google Scholar] [CrossRef] [PubMed]
- Scholz, C.; Eckert, B.; Hagn, F.; Schaarschmidt, P.; Balbach, J.; Schmid, F.X. SlyD proteins from different species exhibit high prolyl isomerase and chaperone activities. Biochemistry 2006, 45, 20–33. [Google Scholar] [CrossRef]
- Chuprov-Netochin, R.N.; Amarantov, S.V.; Shneider, M.M.; Sykilinda, N.N.; Filchikov, M.V.; Ivanova, M.A.; Mesyanzhinov, V.V.; Miroshnikov, K.A. Peptidyl-prolyl isomerase SLyD controls the recombinant folding of bacteriophage T4 long tail fiber fragments. Russ. J. Biopharm. 2011, 3, 30–36. [Google Scholar]
- Huys, I.; Pirnay, J.P.; Lavigne, R.; Jennes, S.; De Vos, D.; Casteels, M.; Verbeken, G. Paving a regulatory pathway for phage therapy. Europe should muster the resources to financially, technically and legally support the introduction of phage therapy. EMBO Rep. 2013, 14, 951–954. [Google Scholar] [CrossRef]
- Housby, J.N.; Mann, N.H. Phage therapy. Drug Discov. Today 2009, 14, 536–540. [Google Scholar] [CrossRef]
- Summers, W.C. Bacteriophage therapy. Ann. Rev. Microbiol. 2001, 55, 437–451. [Google Scholar] [CrossRef]

| Bacteriophage a | Host Range | Host Receptor b | Example Phage | References |
|---|---|---|---|---|
| Podoviruses | ||||
| φYeO3-12 [NC_001271.1] | Y. enterocolitica O:1; O:2; O:3 | O-PS | Similar to Enterobacteria phage T7 | [30] |
| vB_YenP_AP5 [KM253764.1] | Y. enterocolitica O:1; O:2; O:3 | O-PS | Similar to Enterobacteria phage T7 | [31,32] |
| phiYe-F10 [KT008108.1] | Y. enterocolitica O:3 | O-PS | Similar to Enterobacteria phage T7 | [33] |
| vB_YenP_AP10 [KT852574] | Y. enterocolitica O:1, O:2, O:3, O:6, O:6,31, O:35,36, O:41(27), K1 Y. mollareti O:3 Y. frederiksenii O:3 and O:35 Y. intermedia O:52,54 | O-PS in O:3 strains | Similar to Enterobacteria phage T7 | [31] |
| φR8-01 [HE956707.1] | Y. enterocolitica O:3 (O-PS and OC negative strains b) | IC | Similar to Enterobacteria phage T7 | [34] |
| φ80-18 [HE956710.1] | Y. enterocolitica O:8, O:7,8 | O-PS | Similar to Enterobacteria phage T7 | [35] |
| fPS Group 1 phages (11 closely related phages with phage fPS-7 [LT961840] as type species) | Y. enterocolitica O:3 | O-PS | Similar to Enterobacteria phage T7 | [28] |
| fPS Group 2 phages (fPS-53, fPS-85, fPS-89 fPS-54-ocr with phage fPS-53 [LT962379] as type species) | Y. enterocolitica O:3 | OC could be the receptor for fPS-53, fPS-85, and fPS-89; probable Omp as a receptor for fPS-54-ocr | Similar to Enterobacteria phage T7 | [28] |
| fPS Group 3 phages (phage fPS-59 [LT961845]) | Y. enterocolitica O:3 | O-PS | Similar to Enterobacteria phage T7 | [28] |
| fHe-Yen3-01 [KY318515] | Broad host range infecting (29.2%, 31/106) of the Yersinia strains tested | Unknown | Similar to Enterobacteria phage T7 | [36] |
| Siphoviruses | ||||
| φR2-01 [HE956708.1] | Y. enterocolitica O:8 (O-PS negative strains b). | BtuB | Similar to Enterobacteria phageT5 | [37] |
| PY-54 [NC_005069.1] | Y. enterocolitica O:5, O:5,27, Some Y. enterocolitica Biotype 1A strains | Unknown | Similar to phage λ | [38,39,40] |
| Myoviruses | ||||
| PY-100 [AM076770.1] | Y. enterocolitica O:3, O:5,27, O:8, O:9, some Biotype 1A strains, and some untypeable strains Y. pestis Y. pseudotuberculosis Y. intermedia Y. kristensenii Y. frederiksenii Y. rohdei Y. mollareti | Unknown | Similar to phiPLPE-like phages (Dwarf Myoviruses) | [41,42,43] |
| φR1-37 [NC_016163.1] | Y. enterocolitica O:1, O:3, O:5, O:5,27, O:6, O:6,31, O:9, O:21, O25,26,44, O41,43, O41(27)43, O:50. Y. intermedia O:52,54 Y. similis | OC in O:3 | Similar to Pseudomonas aeruginosa phage φKZ | [41,42] |
| φR1-RT [HE956709.1] | Y. enterocolitica O:1, O:2, O:3, O:5, O:5,27, O:6, O:7,8, O:9 | OmpF and IC of LPS | Similar to Enterobacteria phage T4 | [44] |
| vB_YenM_TG1 [KP202158.1] | Y. enterocolitica O:1, O:2, O:3, O:5, O:5,27, O:6, O:7,8, O:9 | OmpF and IC of LPS | Similar to Enterobacteria phage T4 | [44] |
| fHe-Yen9-01 [KY593455] | Broad host range infecting 61.3%(65/106) of the Yersinia strains tested 65.4% (53/81) of the Y. enterocolitica strains tested | Unknown | Similar to Enterobacteria phage T4 | [36] |
© 2019 by the authors. Licensee MDPI, Basel, Switzerland. This article is an open access article distributed under the terms and conditions of the Creative Commons Attribution (CC BY) license (http://creativecommons.org/licenses/by/4.0/).
Share and Cite
Leon-Velarde, C.G.; Jun, J.W.; Skurnik, M. Yersinia Phages and Food Safety. Viruses 2019, 11, 1105. https://doi.org/10.3390/v11121105
Leon-Velarde CG, Jun JW, Skurnik M. Yersinia Phages and Food Safety. Viruses. 2019; 11(12):1105. https://doi.org/10.3390/v11121105
Chicago/Turabian StyleLeon-Velarde, Carlos G., Jin Woo Jun, and Mikael Skurnik. 2019. "Yersinia Phages and Food Safety" Viruses 11, no. 12: 1105. https://doi.org/10.3390/v11121105
APA StyleLeon-Velarde, C. G., Jun, J. W., & Skurnik, M. (2019). Yersinia Phages and Food Safety. Viruses, 11(12), 1105. https://doi.org/10.3390/v11121105

